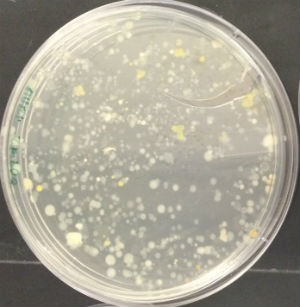

User:Student 60/Notebook/Biology 210 at AU
Zebra Fish Experiment - Retinoic Acid (Vitamin A) - March 3, 2016
PURPOSE
The purpose of this experiment is to observe the effects of Retinoic Acid, more commonly known as Vitamin A, on the embryological development of Zebra Fish. Considering zebrafish are model organisms due to their sensitivity to environmental changes, it is likely that the fish embryos treated with vitamin A will present with stunted growth, tail or spinal deformities, a decrease in activity, and/or have increased mortality rates when compared with the control group.
MATERIALS AND METHODS
- Zebrafish embryos (48 total - 24/per well)
- Deerpark water (with anti-fungal methylene blue treatment)
- Petri dishes (2)
- Transfer pipettes
- 10^-10 M of Retinoic Acid (Vitamin A)
- P-1000 Pipette
- Dissection microscope
- Shrimp (to feed Zebrafish post-hatching)
- Depression slides
- Camera phone
To begin, zebrafish embryos were observed to determine their stage of development on the first day of the experiment (Day 0 on Table). A total of 48 zebrafish embryos were transferred to a petri dish using a transfer pipettte to be sorted into a 24-well control group tray and a 24-well treated (Retinoic Acid - Vitamin A) group. Each tray was labeled as 'control' vs. 'treated,' making sure to include group member names, the date, and number of embryos. Next, our group created an observation schedule, which we determined to be midday on Monday, Wednesday, and Friday over the course of two weeks. Observations for the first day were made, keeping in mind that the first few days would be the period when a great deal of development would be taking place. On day 4-5, after the zebrafish hatched, the empty egg cases were removed prevent mold from growing within each week in both the control and treated groups. For each observation visit, 1 ml of the treated Deerpark water was removed from each well in the control group and replaced with fresh treated Deerpark water. The same was performed with the treated group, only with the 10^-10 M Retinoic Acid instead of the treated Deerpark water.
DATA AND OBSERVATIONS

Table 1. Observational Log for Days 0-11 of the Zebrafish Control Group


Table 2. Observational Log for Days 0-11 of the Zebrafish Treated Group
CONCLUSIONS AND FUTURE DIRECTIONS
One of the most notable differences between the control and treated groups was the latter's vibrant yellow pigmentation and increased activity level between Day 4 and Day 9. It was not until after Day 9 that the treated group began to present with increasingly angled tails/spines and when their tails bent more than 130° (approaching 90°), the rate of mortality increased, but only slightly. Only 1 out of 19 treated live hatchlings died, while most in the treated group thrived despite their tail deformities. Another marked difference between the control and treated groups was their overall sizes (in μm). On average, the treated fish were slightly longer. On Day 11, they reached an average of 30 μm in length where as the fish in the control group grew to be just over 26μm in length on average. Interestingly, the control group were not only smaller and less active than the treated group, they also presented with a much higher rate of mortality than the treated group. By Day 4, only 15 of the zebrafish embryos had hatched and a total of 8 had disintegrated into a yellow clump of mass. By Day 11, the control groups numbers dropped from 15 to 11 live hatchings. One possible explanation for this is that somehow the pH of the Deerpark water treated with anti-fungal methylene blue was either too high or too low when it should have hovered around a pH of 7. It is also possible that other environmental factors (or human error) could have contributed to the higher drop off in the control group (i.e. light exposure, failing to replace each well with a full 2mL of treated Deerpark water, etc.). Moving forward, it would be interesting to determine the threshold of the concentration of retinoic acid (in M) that zebrafish could withstand before they would present with tail/spinal deformities.
VW
16S Sequence Analysis of Bacteria Cultures - February 25, 2016
PURPOSE
The purpose of this experiment is to identify bacteria species that exist within transect #2 first using Polymerase Chain Reaction (PCR) sequencing to amplify bacterial genomic DNA and then gel electrophoresis to test for the 16S gene. This particular gene is tested for because it possesses sequences of DNA that are particular to specific types bacteria. Confirming its presence allows us to check existing databases to match results with the genomes of existing bacterial species.
MATERIALS AND METHODS
- Latex gloves
- Agarose gel
- Gel box and lid
- Stainless steel wire
- 9V batteries
- UV box light
- (4) microliter tubes
- P-100 pipette
- Centrifuge machine
- PCR mixture
To begin, samples from group #2's Hay Infusion Culture were diluted and mixed sterile broth to encourage bacterial growth and then transferred onto nutrient agar and nutrient plus tetracycline plates. These plates were then left to incubate for a week. Next, two sample from each type of plate (with and without tet) were isolated and added to 100μL of water in 4 200 μL tubes with caps. These tubes were then incubated in a heated water bath (at ~ 100°C). After several minutes, these samples were then centrifuged for 5 minutes. Following this process, 5μm of the newly created supernatant fluid was added to 20μL of PCR mix consisting of primers and polymerase in a newly labeled tube. After another week, the PCR product was stained and placed in the electrophoresis box. Next, the samples were pipetted into the top starting wells of the gel along the ladder using a P-100 pipette. It is important to note that the gel was placed with the starting wells in the direction of the negative charge to ensure the DNA samples would travel toward the positively charged end of the gel once the electrical charge was turned on. The gel was placed with the well facing the negative charge so that the DNA product would travel toward its positive end after initiating the electrical field. The two samples that were not used in this process were sent out for sequencing. The resulting sequences were then copied into a 'Blast' database in order to identify the exact bacterial species.
DATA AND OBSERVATIONS
MB43 (16s Sequence from Agar plate with Nutrient 10^-5):
GGNNNNNNNNNNNNNNNNANNNTGCAGTCGTACAGGTAGCCGTAANTTGCTCTCGGGTGACGAGTGGCGGACGGGTGANT MB43 GGNNNNNNNNNNNNNNNNANNNTGCAGTCGTACAGGTAGCCGTAANTTGCTCTCGGGTGACGAGTGGCGGACGGGTGANTAATGT
CTGGGAAACTGCCTGATGGAGGGGGATAACTACTGGAAACGGTAGCTAATACCGCATAACGTCGCAAGACCAAAGAGGGGGACCTT
CGGGCCTCTTGCCATCAGATGTGCCCAGATGGGATTAGCTAGTAGGTGGGGTAATGGCTCACCTAGGCGACGATCCCTAGCTGGTC
TGAGAGGATGACCAGCCACACTGGAACTGAGACACGGTCCAGACTCCTACGGGAGGCAGCAGTGGGGAATATTGCACAATGGGCG
CAAGCCTGATGCAGCCATGCCGCGTGTATGAAGAAGGCCTTCGGGTTGTAAAGTACTTTCAGCGGGGAGGAAGGTGTTGTGGTTAAT
AACCGCAGCAATTGACGTTACCCGCANAANAAGCACCGGCTAACTCCGTGCCAGCANCCGCGGTAATACGGANGGTGCAAGCGTTA
ATCGGNAATTACTGGGCGTAAAAGCGCACGCAGGCGGTCTGTCAA GTCGGATGTGAAANTCCCCCGGGCTCAACCTGGGAACTG
MB44 (16s Sequence from Agar Plate with Nutrient and Tetracycline 10^-3):
NNNNNNNNNNNNNNNNCNNNNNNNNGACAGCCGAGCGGTAGAGATCTTTCGGGATCTTGAGAGCGNGCGNTACGGGTGCGGANC
NNNTGTGCAACCTGCCTTTATCAGGGGGATAGCCTTTCGAAAGGAAGATTAATACCCCATAATATATTGAATGGCATCATTTGATATTG
AAAACTCCGGTGGATAGAGATGGGCACGCGCAAGATTAGATAGTTGGTAGGGTAACGGCCTACCAAGTCAGTGATCTTTAGGGGGCC
TGAGAGGGTGATCCCCCACACTGGTACTGAGACACGGACCAGACTCCTACGGGAGGCAGCAGTGAGGAATATTGGACAATGGGTGA
GAGCCTGATCCAGCCATCCCGCGTGAAGGACGACGGCCCTATGGGTTGTAAACTTCTTTTGTATAGGGATAAACCTTTCCACGTGTGG
AAAGCTGAAGGTACTATACGAATAAGCACCGGCTAACTCCGTGCCAGCAGCCGCGGTAATACGGAGGGTGCAAGCGTTATCCGGATT
TATTGGGTTTAAAGGGTCCGTAGGCGGATCTGTAAGTCAGTGGTGAAATCTCATAGCTTAACTATGAAACTGCCATTGATACTGCAGGT
CTTGAGTAAANGTANAAGTGGCTGGAATAAGTANTGTANCGGTGAAATGCATAGATATTACTTANAACACCNATTGCGANNCAGGTCAC
TATGNTTTAACTGACGCTGATGGACGAAAGCGTGGGGAGCGAACNGGATTANATACCCTGGGTAGTCCACGCCGTAAACNATGCTAA
CTCGTTTTTGGNCTTTAGGGTTCAGANACTAAACNAAAGTGATNAGTTAAGCCNCCTGGGGANTACGTTCGCAAGAATGAAACTCANA
GGAATTGAACGGGGGCCCGCACACCGGGGGATTATGTGGTTTANTNNNATNANTCNCANGGAACCNTACCANGCTAAATGGGNATTG
ANGGGTNNNNANTAGACTTTCTTCNANNNTTTCAANGNNCTNCATGGGTGGNNGNGNGCTNNNGCNNNNAAGNNNNNNNN
MB43 Species ID: Enterobacteriaceae Bacterium S2A 16s ribosomal RNA gene, 97% match (Below)
MB44 Species ID: uncultured bacterium clone, 95% match
CONCLUSIONS AND FUTURE DIRECTIONS
The sequencing (16s) of MB43 identified the following bacterial species: Enterobacteriaceae Bacterium. This bacteria is rod-shaped and gram-negative, which is inconsistent with the data collected from transect #2. All of the bacteria we grew in culture, were gram-positive and cocci. Considering that the data collected for the above 16s sequencing was taken by another group in a previous year, but form the same transect, it is possible that the Enterobacteriaceae Bacteria were present in a different part of the transect--one that our current group did not take a sample from. Furthermore, the sequencing of the MB44 bacterial sample, proved to be of poor quality. The blast identified this sample to be an uncultured bacterium clone, 95% match. Perhaps, it is possible that this is a species of bacteria whose genome has not yet been mapped or entered into the database, but it may be more likely that the sample was of poor quality.
VW
Identifying and Studying Invertebrates and Vertebrates - February 18, 2016
PURPOSE
The purpose of this experiment is to identify, using a dichotomous key, the types of invertebrates that inhabit transect#2 using the Berlese Funnel prepared a week in advance. Examining any existing invertebrates will offer insight into the morphological characteristics of invertebrates--specifically in terms of symmetry (radial vs. bilateral), differences in mechanisms of motility between the organisms present, germ tissues (endo, ecto-, and mesoderms, and whether the organisms examined can be classified as coelomates, acoelmomates, or pseudocoelmates. In terms of biodiversity, there is a chance that the remnants of group #2's Berlese Funnel will contain a conservative number (fewer than 10) of only a few types of insects (invertebrates) due to the stark temperature changes (from -5°C to 10 °C) that have been at play over the course of the past few weeks.
MATERIALS AND METHODS
- Petri dishes
- Berlese Funnel (previously prepared)
- Transfer pipettes
- Dichotomous key (hope.edu webportal)
- Dissecting microscope
- Camera phone
To begin, group #2 carefully removed its Berlese Funnel from its stand and gently poured the top 10-15 mL of 50% ethanol (including any organisms present) equally into two separate petri dishes. We examined both dishes using a dissecting microscope, using a probe when necessary to get a better view of the organisms. Next, group #2 used the dichotomous key (provided by hope.edu) to identify the class of Anthropoda invertebrates we discovered.
DATA AND OBSERVATIONS
Unfortunately, a group from a different Biology 210 section used group #2's Berlese funnel collection sample. As a result, there were fewer organisms for our group to identify between equally divided samples (each place in a separate petri dish; two total) observed under the dissecting microscope. Nonetheless, of the organisms were were able to identify, most were concentrated in one dish, with the largest was what we identified to be a grasshopper at 8.5 millimeters in length. There was a tie for second largest between the plant lice and springtail, which were both 4 millimeters long. The smallest organisms were the cicada and fly, which we measured to be 3.5 and 1.2 millimeters long respectively. Group #2 were able to examine a total of 3 springtails within our funnel collection. This makes sense considering their natural habitat includes moist, soily, decomposing leaf litters. Though, given their propensity to use tail-like appendages at the base of their abdomen to flee when threatened, it is interesting that the springtails found within our leaf litter did not manage to escape. It is also possible that they were simply embedded between our leaf litter as were the other organisms examined during this experiment.
Table 1. Classification and Characteristics of Invertebrate Organisms Inhabiting Transect #2






Table 2. Potential Vertebrate Species Inhabiting Transect #2





Figure 1. Microorganism to Vertebrate Species Food Chain
Many of the organisms that inhabit transect #2 are included in the food chain depicted above--the largest of these organisms being grasshoppers and springtails and the smallest, gram-positive cocci bacteria. This food chain demonstrates the relationships between the organisms living in the same environment, occupying separate and overlapping niches, at the point in time.
CONCLUSIONS AND FUTURE DIRECTIONS
The organisms found within transect #2, ranging from the unicellular eukaryotes all the way to the multicellular invertebrates, comprise an ecological community, as they all occupy the same geographical area at the same time. Each organism fills a niche that is directly correlated with their respective trophic levels within their immediate environment, which in this case is transect #2. For instance, springtails hold a higher position on the food chain than microorganisms such as fungi, decomposing foliage, algae, and even feces. Algae, while they are consumed by invertebrates such as the aforementioned springtails, hold a higher trophic level than bacteria, which they consume. The prey-predator relationships between these organisms, large to the microscopic, as well as their respective or shared niches plays a large role in the carrying capacity of their natural habitats. No matter what an organism consumes, there is a limit, or carrying capacity, to the number of species that can occupy the same environment at the same time due to natural constraints on food, living space, and water.
VW
Identifying and Studying Plants and Fungi - February 11, 2016
PURPOSE
The purpose of this experiment is to describe the definitive characteristics of fungi and explain how they differ from plants. This is accomplished by comparing and contrasting plant samples taken from transect #2 and fungi samples, specifically Rhizopus stolonifer,black bread mold provided in lab. Essentially, the goal is to become more familiar with the specific traits that differentiate the two kingdoms. I predict that since plants have chlorophyll and as a result, are able to photosynthesize and produce their own food (autotrophs) and fungi are decomposers and heterotrophic symbionts that their morphologies will be starkly different to suit their respective metabolic pathways. This will also be the case when considering their mechanisms of reproduction.
MATERIALS AND METHODS
- Latex gloves
- Lab Coat
- Ziploc bags
- Dissection scope
- Microscope
- Razor blades (dissect seeds)
- Conical tube (50 mL)
- 50:50 ethanol/water solution
- Screening material (1 sq. inch)
- Funnel
- 40 watt lamp
- Clamp
- Aluminum Foil
Procedure I: Collecting 5 Samples from Transect #2
To begin, Group #2 collected a leaf litter sample as well as representative, diverse samples from transect #2 of (5) plants, specifically any leaves, flowers, seeds, or pine cones. Photos were taken of any trees in the area and branches collected to aid in the identification of the genus.
Procedure II: Plant Vascularization
A sample of moss, Mnium, was compared with the stem of the Angiosperm, lily. The height of the moss versus the lilly was observed as well as a cross section slide of the lilly stem, which allowed us to locate the xylem and phloem layers within its stem.
Procedure III: Presence of Specialized Structures
The leaves of moss were examined using a dissection scope. We specifically examined what appeared to be distinct stems and leaves, but are photosynthetic appendages. Its smooth surfaces were also noted, which are indicative of its waxy cuticle.
Procedure IV: Mechanisms of Plant Reproduction
The moss, Polytrichum was examined in order to identify the male and female gametophytes (haploid) and sporophyte (diploid). Next, a lily flower was dissected in order to identify its reproductive parts: the anther, stigma, stamen, style, filament, and ovules within its ovary. Finally, lab seeds were dissected along with seeds collected from transect #2 in order to identify its component parts: the embryo, food source (yolk), and seed coating.
Procedure V: Observing Fungi
Black bread mold in a petri dish was examined with a dissecting scope with the top on. The mass of white hyphae filaments, also referred to as the mycelium, growing over the surface of the agar containing various organic compounds were noted. Small black round structures called sporangia, where the fungi spores are held, were also noted. The agar dish was then turned over to locate small, root-like hyphae called rhizoids growing into the agar.
Procedure VI: Setting up the Berlese Funnel to Collect Invertebrates
To begin, 25 mL of 50:50 ethanol/water solution was placed in a 50 mL conical tube. Next, a 2x2 inch piece of screening material was inserted into the bottom of a funnel. The sides of the screening material was taped to the inside of the funnel bottom to ensure it would stay in place. The leaf litter collect from transect #2 was carefully layered into the large opening, or top, of the funnel until no more leaves could fit on top. The funnel was then clamped to a ring stand so that it would remain in place and positioned beneath a lit 40 watt lamp (with an incandescent bulb) with 1-2 inches of space between it and the top of the leaf litter. The final step was to cover the entire mechanism with aluminum funnel. The organisms that would filter into the conical tube are to be used the following week with the purpose of examining invertebrates.
DATA AND OBSERVATIONS

(Source: https://gobotany.newenglandwild.org)











Fungi sporangia are asexual sacs where spores are formed and released. They are important because they are one of the reproductive mechanism by which fungi reproduce. The bread mold, as pictured below, can be classified as a fungus because it has a mycelium with tightly compacted hyphae and sporangia with what I imagine contain spores. As a result, it can be classified as hailing from zygomycota.


CONCLUSIONS AND FUTURE DIRECTIONS
Generally, the prediction that plants and fungi would be starkly different in terms of their morphology was correct. Though, it is important to note that there are similarities between the two kingdoms: fungi and plants are both eukaryotic, multicellular, non-motile, and can both undergo their own forms of alternation of generations to produce gametes, spores, and seeds as far as reproductive mechanisms are concerned. Beyond this, plants and fungi are not all that similar.
For instance, plants are autotrophic and can synthesize their own food via a photosynthetic metabolic pathway. Fungi, however, are heterotrophs and must attain their nutrient supply from another source, which is why generally they are classified as symbionts because, as mycorrhiza they form mutualistic relationships with plants. In this way, fungi are more closely related to humans than plants. Furthermore, fungi reproduction can consist of zygosporangia, fused hyphae from two individuals forming a new structure, gametes and spores that swim in water, basidia (i.e mushrooms) that form at the ends of hyphae producing 4 spores, and asci, sacs containing cells that undergo meiosis and form 8 spores. Plants are able to reproduce both sexually (meiosis) and asexually (mitosis) to produce seeds, but using different structures (i.e. mature flowers). These differences were solidified during this experiment when comparing the sporangia of the Rhizopus stolonifer, bread mold versus the mature flower of the lily plant.
VW
Identifying and Studying Bacteria - February 28, 2016
PURPOSE
The purpose of this experiment is to use qualitative and quantitative methods to examine the microorganisms living within group #2 Hay Infusion Culture. This week in particular, the focus is on bacteria and testing for antibiotic resistance. This is accomplished by allowing serial dilutions of bacteria to grow on nutrient rich agar plates, half of which have been supplemented with tetracycline, a broad-spectrum antibiotic. The cultures were allow to incubate for a about a week and the results were quite telling.
MATERIALS AND METHODS
- Latex gloves
- Lab Coat
- Bunsen Burner
- Agar plates (with incubated bacteria cultures from the previous week's serial dilutions)
- Microscope
- Glass slide and cover slips
- Metal transfer loop
- 95% alcohol
- Graham's iodine
- Safranin Stain
- Distilled water (in wash bottle)
- Kimwipes
To begin, one final observation of group #2's Hay Infusion Culture was made, noting any changes in smell and/or appearance. Our culture in particular remained orderless, but in terms of what used to be three distinct layers (top, middle, and bottom), now only consisted of a top and bottom layer with the surface of the culture being uncharacteristically clear and free of any notable organisms (i.e. algae or mold). I suspect that this may be due to a stark decrease in available nutrients. As a result, the organisms that thrived on the dried milk added to the culture died off or the habitat became uncondusive to life. It is for this reason that Archaea species would thrive if grown on agar plates since they require a steady source of nutrients, which the plates proved. Beyond this, about 50% of the water volume remained. It likely evaporated as a result of direct exposure to sunlight.
Final Hay Culture (Final Stage: 3-4 Weeks)

Procedure I: Quantifying and Observing Bacteria and Bacterial Colonies
In order to identify the type of bacteria growing on our agar plates, we first made note of the morphological characteristics of our bacterial colonies and then counted the colonies present on each plate, making sure to divide our results by 100 since our culture was make using 100 microliters. This ensureed our units remained consistent (#colonies/micrometer).
Procedure II: Testing for Antibiotic Resistance The Mechanism of Action of Tetracycline
Tetracycline antibiotics are protein synthesis inhibitors. Essentially, they inhibit the binding of aminoacyl-tRNA to the mRNA-ribosome complex by binding to the 30S ribosomal subunit in the mRNA translation complex. The types of bacteria that are sensitive to this antibiotic are Gram-positive. Source: http://www.ncbi.nlm.nih.gov/pmc/articles/PMC99026/
DATA AND OBSERVATIONS
Table 1: Observing Bacteria Cell Morphology

Table 1. 100-fold Serial Dilutions Results
From this data, there is a stark difference between the agar plates containing tetracycline, a broad-spectrum antibiotic, and those without it. Many of the bacteria cultures, 10^-5, 10^-7, 10^-9 nutrient + tet plates, did not show signs of antibiotic resistance. Absolutely no bacteria grew on these plates. The 10^-3 nutrient + tet plate, however, did show signs of antibiotic resistance and grew approximately 23 colonies.

Table 2. Descriptions of bacterial cell colonies after agar gel plating of serial dilutions.

CONCLUSIONS AND FUTURE DIRECTIONS
The importance/significance of the gram-staining process is what became the most apparent while conducting this particular lab. By determining whether bacterial strains are gram positive or negative, it is possible to pinpoint the best way to neutralize that particular strain. Gram positive strains of bacteria, like the ones group #2 examined for this experiment, have a thick layer of peptidoglycan in their cell wall and as a result have a natural resistance to broad-spectrum antibiotics such at tetracycline. From this, it would be interesting to research ways to penetrate or dissolve gram positive bacteria's peptidoglycan wall to combat their antibiotic shield.
VW
Good entry, barring the missing info which we had discussed. I like the pictures. - Pragati
Hay Infusion Culture: Taking a Microscopic Look - January 21, 2016
PURPOSE
The purpose of this experiment is to identify microorganisms growing on the surface, middle, and bottom of Group #2's Hay Infusion Culture, while considering the biotic and abiotic factors residing in each level of the culture. If the presence of photosynthetic microorganisms, such as algae, are present in the culture, then it is likely that algae will exist closest to its surface for maximum exposure to the sun. Also, if protists reside within Group #2's Hay Infusion Culture, then it is likely that they will be found near its top layer layer as well since protists, such as Paramecium, eat plankton which is found in the layers closest to the surface of the water.
MATERIALS AND METHODS
- Hay Infusion Culture (*prepared previous week)
- Latex Gloves
- Microscope
- (6) Slides and slide covers
- Transfer pipettes
- Dichotomous Key (*aid in identifying microorganisms)
DATA AND OBSERVATIONS
(Group #2, upon opening its Hay Infusion culture,
found it to have a very slight "earthy/eggy", but
overall odorless smell)
(Characteristics - brown-yellow in color, non-motile,
photosynthesizing form of algae. This microorganism
meets all the needs of life as described on page 2
of the Freeman text in that it 1. is comprised of
cells, or more specifically, it's unicellular 2. with cell
walls 3. use chlorophyll to harvest energy from the sun
(photosynthesis) 4. able to adapt to their environment
(i.e. forming stalks to attach to water surface) 5. Can
grow by forming larger colonies 6. has an
oogamous sexual reproduction cycle)
(Paramecium: (left) Characteristics - greenish-brown in
color, covered in cilia which allow it to collect food
and be motile unicellular, Eukaryota, protozoa)
CONCLUSIONS AND FUTURE DIRECTIONS
The niche where most of Group #2's organisms were found was the top layer of the Hay Infusion Culture. This makes sense considering the top layer would have had the most direct exposure to sunlight, attracting photosynthesizing organisms such as diatoms. Paramecium would also be drawn to the surface of the culture to be near one of its primary food sources: photosynthetic algae.
If the Hay Infusion Culture had been allowed to grow for an additional two months, it may be that the microorganisms growing within it would reproduce, gradually approaching their respective carrying capacities. This would lead to an increased competition for resources and a lab-friendly window into a microscopic survival of the fittest scenario.
SERIAL DILUTIONS DIAGRAM: (In Preparation for Next Week's Bacteria Quantification Lab)

VW
Examining Biological Life at AU - January 7, 2016
PURPOSE
The purpose of this experiment is to observe and describe the topograhic, biotic, and abiotic characteristics of a 20 by 20 foot transect on American University's Main Campus by creating a Hay Infusion Culture, or lab-friendly ecosystem. This makes it possible to examine the breadth of biodiversity (or lack thereof) within a finite plot of land on campus. Considering one of the features of the transect observed in this experiment, just North of the AU campus Amphitheater and Southwest of Leonard Hall, is a small creek with flowing water, boulders and tiny pebbles covered in moss and algae, and fresh, saturated soil, it is likely that a more thorough analysis of the samples taken from Group#2's transect will show there to be more biotic than anbiotic components overall.
MATERIALS AND METHODS
- 1 Gallon Ziplock Bag
- Latex Gloves
- Flashlight (*transect observed after dark)
- Camera/camera phone
- Glass Jar (w/ 1L capacity) with lid
- 500ml of purified water
- 0.1 gram of dried milk (*sustenance for living organisms in hay infusion culture)
- Sharpie
- Painter's tape or labels
Group #2 collected roughly 10-12 grams worth of samples from its transect which consisted of a sloping bank leading down to a small creak with gently flowing water. The biotic components collected included moss, algae, and reeds. The abiotic components included water (not including the micro-organisms within it), soil, dead leaves, drift wood, and small pebbles. The living organisms were collected from the creek; the nonliving organisms were taken from the bank leading down to the creek. These samples were then added to a gallon-sized ziplock bag and 10 grams worth of samples were added to a 1 liter glass jar along with 500 ml of purified Deer Park water and 0.1 grams of dried milk. A lid was placed over the glass jar and the contents were gently shaken to evenly distribute the dried milk.
DATA AND OBSERVATIONS

Biotic Organisms:
- Mold - surface level of creek
- Algae - surface level of creek
- Water reeds - near edge of soil bank leading down to creek
- Moss - surface of surrounding trees
Abiotic Organisms:
- Water (not including the organisms living within it) - within creek
- Soil - near bank of creek
- Detached leaves/foliage -found covering entire transect
- Driftwood - near bank of creek
- Boulders - atop bank of creek (north and south)
- Small pebbles - within the creek
CONCLUSIONS AND FUTURE DIRECTIONS
Group #2's transect contained a great deal of water, soil, moss, and algae. Where there is water, there is life. As a result, moving forward, I predict that there will be either a great diversity of microorganisms to classify in our next lab, or there will be a larger groups of only a few types of microorganisms.
VW



